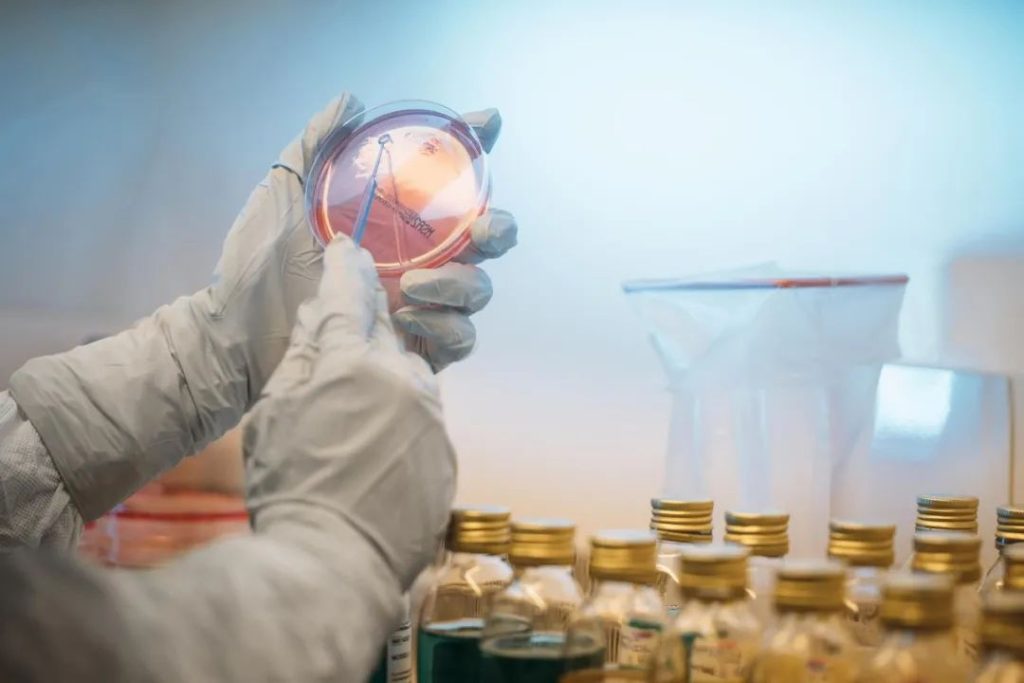

高德美 | 旗下三款「美学产品」数据发布,彰显行业「领导地位」
- 网络
- 浏览
- 2025-02-23 15:33
2025年2月1日,全球专业皮肤健康公司高德美Galderma公司在2025 IMCAS大会期间,展示公司旗下三款创新美学产品组合的最新数据,主要产品包括新型液态A型肉毒毒素、塑妍萃®和瑞蓝®系列。
据悉,塑妍萃®作为全球首款原研注射用聚左旋乳酸填充剂,采用独特的PLLA-SCA配方,其具有强大的再生特性,并能对皮肤三层结构起作用,同时,将塑妍萃®与Alastin®联合用于中面部,能产生协同效果并提升患者体验;新型液态A型肉毒毒素作为首款且唯一一款通过 PEARL技术研发的即用型液态肉毒毒素,在长达12个月内对中重度眉间纹治疗时,高达39%的患者从第一天起就看到效果,高达75%的患者在治疗眉间纹和鱼尾纹后可在6个月内维持改善;瑞蓝®系列产品中,瑞蓝®Refyne和瑞蓝®定采®不仅能提升面部吸引力和年轻感,还能在面部静态和动态表情保持自然感,瑞蓝®SHAYPE采用高德美创新的NASHA HD技术,具备更高的交联效率和更高的HA含量,数据显示其G值为现有HA填充剂中最高,表明其凝胶强度和硬度更优,非常适合用于下面部塑形。高德美作为皮肤学领域的全球领导者,公司产品覆盖注射美学、日常护肤和皮肤治疗三大领域,在注射医美领域的品牌有Dysport肉毒素、Restylane注射透明质酸和Sculptra左旋聚乳酸。2009年高德美和益普生Ipsen达成许可协议,获得肉毒毒素产品Dysport吉适的经销权;2022年高德美在欧洲推出了全球首款即开即用型液态A型肉毒毒素产品Alluzience。
关于高德美
高德美公司成立于1981年,由雀巢和欧莱雅集团联合创立,专注研发和营销皮肤病医疗解决方案,致力于为世界提供创新的、以科学为基础的优质旗舰品牌和服务组合,横跨注射美学、日常护肤和皮肤治疗这三个快速增长的皮肤学细分市场,在全球大约90个国家和地区开展业务。
高德美作为皮肤学领域的全球领导者,公司业务涵盖医美、化妆品和处方药,其中医美领域涉及透明质酸填充剂、肉毒素和童颜针,核心代表产品为聚左旋乳酸微球-Sculptra、玻尿酸-瑞蓝Restylane和肉毒素-吉适Dysport。
2009年,高德美与益普生IPSEN已建立战略伙伴关系,Dysport吉适是英国IPSEN药厂生产的A型肉毒素,诞生于1990年,1999年通过CE认证,2009年通过FDA认证,2020年获国家药监局批准,成为国内获批的第三款A型肉毒毒素。
2010年高德美溢价收购Q-med整合升级透明质酸针剂产品线,Q-Med 产品线主要有美容产品(瑞蓝Restylane系列)和医疗保健产品两类,其中,透明质酸填充针剂共计10款产品都同属Restylane系列。
2021年4月29日,高德美旗下注射填充透明质酸产品瑞蓝®丽瑅已获批中国内地首个鼻背和/或鼻根塑形适应症,注册证号:国械注进20183460227。
除此之外,瑞蓝旗下的两款含利多卡因的注射填充透明质酸产品,瑞蓝®瑞瑅,注册证号:国械注进20203130045,瑞蓝®丽瑅·丽多,注册证号:国械注进20203130098,均已于2020年获批上市。
2021年11月7日,高德美旗下注射填充透明质酸产品瑞蓝®定采已获得国家药监局批准,用于面部真皮组织中层至深层填充以纠正中度至重度鼻唇沟皱纹,注册证号:国械注进20213130059。
2023年1月16日,高德美旗下注射填充透明质酸产品瑞蓝®丰采正式获得国家药监局批准,注册证号:国械注进20233130011,用于矫正中面部容量缺失和或中面部轮廓缺陷,注射层次为皮下、骨膜上层。
2023年3月24日,高德美旗下注射填充透明质酸产品瑞蓝®定采获的国家药监局批准,用于注射到骨膜上,填充下颌区域,以改善轻度至中度下颌后缩患者的下颌轮廓,这是瑞蓝®定采在国内上市以来获批的”第二个“适应症,也是国内”首个且唯一“获批下巴适应症的注射填充玻尿酸产品。
2023年4月26日,高德美旗下的注射用聚左旋乳酸“童颜针”Sculptra®获得美国FDA批准新的适应症:面颊部细纹和皱纹矫正(面颊部除皱),同时Sculptra也是首个获得FDA批准的“面颊部除皱”适应症的PLLA型胶原刺激剂。
2023年6月5日,高德美旗下注射填充透明质酸产品瑞蓝®Eyelight正式获得美国FDA批准,Eyelight搭配有利多卡因,FDA批准的适应症是21岁以上成人眶下凹陷 (≈黑眼圈),同时产品已于2021年底在欧洲上市,2023年6月在美国上市。
2023年8月1日,高德美旗下注射填充透明质酸产品瑞蓝®丽瑅•丽多用于”鼻背和/或鼻根塑形”正式获国家药监局批准,适应范围变更涵盖”鼻唇沟、中面部和鼻部”三大部位。
2024年1月22日,高德美旗下瑞蓝系列透明质酸新品Restylane®SHAYPEM成功获得加拿大卫生部的批准。据悉,Restylane®SHAYPE专为通过深层注射在骨骼上构建和塑形而设计,具有仿骨效果,适应症为颏部塑形填充,将于2024年2月在加拿大上市。
2024年3月8日,高德美发布2023年度财报,公司实现净销售额40.82亿美元,同比增长8.5%;净利润9.42亿美元,同比增长21.4%。其中,注射美学、日常护肤和皮肤治疗三大业务的净销售额同比增长分别为6.5%、12.1%和8.7%。
2024年4月24日,高德美旗下玻尿酸产品瑞蓝®丰采Restylane®Volyme上市发布会在上海举行。据悉,瑞蓝®丰采主要用于矫正中面部容量缺失和/或中面部轮廓缺陷,注射层次为皮下、骨膜上层。
2024年6月19日,高德美位于瑞典乌普萨拉的卓越生产中心正式获得瑞典药品监督管理局发布的生产许可证,许可其对其研发的即用型液态A型肉毒毒素开展生产和生物分析检测。据悉,RelabotulinumtoxinA是一种创新的、高活性的、不含复合物的、即用型液态A型肉毒毒素,使用专有菌株,并采用独特的先进工艺制造。
2024年8月5日,欧莱雅集团发布公告称,拟收购全球专业皮肤健康公司高德美Galderma公司10%的股份。据悉,欧莱雅表示此次收购是欧莱雅和高德美之间更广泛的战略科学合作伙伴关系的一部分。
2024年9月30日,高德美旗下的”注射用聚左旋乳酸填充剂”Sculptra®塑妍萃®正式获国家药监局批准,注册证号:国械注进20243130557。据悉,Sculptra®是首个获得FDA批准的“面颊部除皱”适应症的PLLA胶原刺激剂,截至目前共有3个适应症获批。
2024年10月24日,高德美Galderma公司对外公布前三季度财报,公司实现营收32.59亿美元,同比增长9.2%。其中,注射美学业务收入16.98亿美元,其中,肉毒毒素贡献9.26亿美元,皮肤填充剂和生物刺激剂贡献7.72亿美元;日常护肤业务收入9.9亿美元;皮肤治疗业务收入5.71亿美元。
本文地址:http://www.quanqiuyimei.com/kuaixun/10.html
高德美 | 旗下三款「美学产品」数据发布,彰显行业「领导地位」快讯1
威脉医疗 | 完成数千万「B+轮」融资,加速「YOUMAGIC」市场化布局快讯2
无限极明星护肤品怎么样?极美白淡斑的效果好吗?快讯3- 快讯睛艺求精,美美与共「眼周年轻化特色诊疗技术共研中心」授牌落成仪式
- 快讯“耳廓美学”面部解剖高级研修班在广东举办
- 快讯莫娜丽莎发表《东方美学泛口周塑美与抗衰专家白皮书》
- 快讯无限极明星护肤品怎么样?极美白淡斑的效果好吗?
- 快讯耀动全国,爱无止境 2025虞美人全国春天联欢晚会成功举办
- 快讯广东省科普作家协会新媒体与医学专委会成立大会在深召开
- 快讯主理人说 | 蒂娜女王金锡勋:“每个女性的独特魅力都值得被珍视和祝福”
- 快讯杜晓岩:数据应用是大湾区口腔产业高质量发展的关键
- 快讯威脉医疗 | 完成数千万「B+轮」融资,加速「YOUMAGIC」市场化布局
- 快讯华熙生物 | 加入「联合国」全球契约组织,推动「全球化」可持续发展
- 快讯韩国医美观察:对话亚洲医美 聚焦注射技术与经管
- 快讯杭州泰利斯有望引领编制牙科增材团体标准